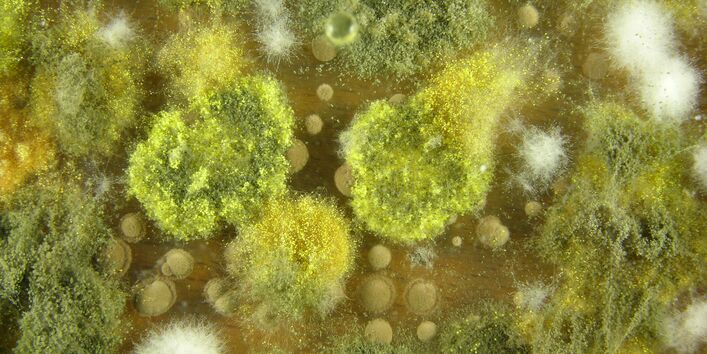
Vergrößerte Aufnahme eines Schimmelpilz mit Sporen

Research for your health
The German Environmental Surveys (GerES) are the largest existing studies on the exposure to pollution of the population in Germany. In the studies, the Federal Environment Agency regularly checks which potentially harmful substances and environmental influences (such as chemicals or noise) people in this country come into contact with. The following are analysed:
- How high the exposure is to individual environmental factors,
- Where individual harmful substances come from,
- By which pathways they enter the human body,
- And under what circumstances individual environmental influences can affect human health.
Up to 5,000 people take part in the GerES. The large number and targeted selection of participants ensures that the results are representative; in other words, they can reliably be used to draw conclusions about environmental impacts on the population as a whole. Thus it is that the study results also serve as a basis for rules and laws for the protection of people and the environment.
The first German Environmental Survey took place between 1985 and 1986. At that time, the focus was on the exposure to pollution of adults in West Germany. Since then there have been three further studies. In 1991, for the first time, the survey included the population of the former GDR; between 2003 and 2006, in GerES IV, the UBA directed its analysis exclusively at children's exposure to pollution of children for the first time. The young generation, as represented by children and adolescents, is also at the heart of the current environmental survey, GerES V. The environmental surveys are part of the nationwide health monitoring programme of the Robert Koch Institute (RKI).